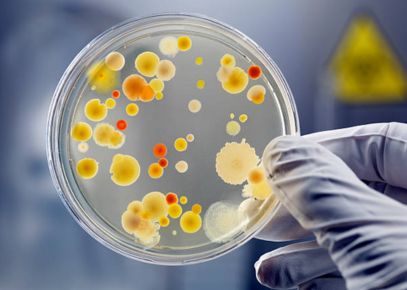

Nuestras Marcas






















Nuestras Marcas























Sobre Nosotros
Con una tradición familiar de más de 30 años dedicados al desarrollo de la importación y comercialización de material científico, ubicados siempre en la ciudad de Valencia, SUMACIEN C.A. se alza con el reconocimiento del sector industrial como uno de los principales proveedores del rubro. El sortear las diferentes etapas que le han tocado vivir a nuestro país, siempre atendiendo y apoyando a nuestros clientes, nos ha hecho más sólidos y competentes, estamos llenos de energía para seguir creyendo y creciendo en Venezuela, seguiremos invirtiendo y esperamos poder acompañar a cada uno de nuestros allegados en sus proyectos por muchos años más.
Nuestro Equipo Humano se dedica a garantizar que nuestros clientes obtengan los mejores productos de acuerdo a sus necesidades. Tanto si busca pipetas graduadas, medios de cultivo o agitadores magnéticos e incubadoras bacteriológicas, tenemos lo que necesita para que desarrolle sus ensayos de manera profesional y asegurando un resultado preciso.
¿Buscas equipos o insumos para laboratorio?
¡Tenemos lo que necesitas!
Si perteneces al área de compras o control de calidad de una empresa, eres analista, investigador, químico o bioanalista y necesitas tener acceso a los suministros necesarios para realizar tus ensayos, entonces, cuentas con nosotros. Estamos seguros que en nuestro amplio stock encontrarás el material más conveniente para cumplir con tus objetivos.
Sumacien C.A.
Suministro de material científico, somos su proveedor confiable de equipos, reactivos para análisis, medios de cultivo, vidriería y artículos para laboratorios de control de la calidad. ¡Esperamos su requisición! Para nosotros será un placer atenderlos.

Nuestros Productos
En SUMACIEN, estamos orientados en atender principalmente las necesidades de los laboratorios de investigación e industriales del área alimenticia, cosmética y farmacéutica. Nuestros clientes en todo el territorio nacional avalan nuestro historial de seriedad y atención personalizada.


Equipos de Laboratorio
◦ Espectrofotómetros
◦ Viscosímetros
◦ Campanas de flujo laminar
◦ Campana de extracción
◦ Refractómetros
◦ Agitador de propela
◦ Balanzas determinadoras de humedad
◦ Balanzas analíticas
◦ Balanzas de precisión
◦ Buretas digitales
◦ Centrífugas
◦ Contadores de colonias
◦ Conductímetros
◦ Phmetros
◦ Medidores de oxígeno disuelto
◦ Medidores multiparamétricos
◦ Rotoevaporadores
◦ Dispensadores
◦ Micropipetas
◦ Auxiliares de macropipeteado
◦ Esterilizadores de asas de siembra
◦ Microscopios
◦ Lupas estereoscópicas
◦ Planchas de agitación
◦ Tamizadores

Vidriería
◦ Cilindros graduados
◦ Condensadores
◦ Beakers
◦ Fiolas
◦ Balones aforados
◦ Pipetas graduadas
◦ Pipetas volumétricas
◦ Placas de Petri
◦ Buretas rectas
◦ Buretas automáticas con pera y envase de 2 litros
◦ Buretas de campo tipo Shilling
◦ Adaptadores con bocas esmeriladas
◦ Balones de destilación
◦ Frascos ámbar y blancos con tapa esmerilada
◦ Frascos de dilución
◦ Frascos graduados autoclavables
◦ Frascos para muestras con tapa rosca
◦ Butirómetros Gerber y Babcock
◦ Celdas de vidrio y cuarzo para espectrofotometría
◦ Celdas Lovibond para colorimetría
◦ Crisoles de cuarzo
◦ Desecador con plato de porcelana y llave para vacío
◦ Crisoles Gooch con frita porosa
◦ Embudos de filtración
◦ Embudos de separación
◦ Equipos de filtración Soxhlet
◦ Frascos goteros
◦ Picnómetros
◦ Pesa filtros
◦ Láminas porta y cubreobjetos
◦ Kitasatos
◦ Sistema de filtración por membranas
◦ Trampas de destilación
◦ Tubos de ensayo
◦ Tubos de centrífuga
◦ Tubos para crioscopio
◦ Varillas de agitación
◦ Viales con tapa
◦ Vidrio reloj
◦ Perlas de vidrio
Microbiología
◦ Agares
◦ Caldos
◦ Medios de cultivo
◦ Placas
◦ Petrifilm
◦ Cuenta colonias
◦ Placas Petri Desechables simples
◦ Placas Petri Desechables dobles
◦ Placas Petri de vidrio
◦ Espátula de Drigalski
◦ Asas de siembra
◦ Mango de Kolle
◦ Mecheros Bunsen
◦ Mecheros de alta temperatura
◦ Esterilizador de asas de siembra
◦ Autoclaves
◦ Incubadoras
◦ Campanas de flujo laminar y bioseguridad
◦ Frascos graduados autoclavables
◦ Fiolas
◦ Papel Parafilm


Plásticos y Gomas
◦ Pisetas
◦ Cilindros graduados
◦ Beakers
◦ Placas Petri simples y dobles
◦ Desecadores
◦ Embudos de filtración
◦ Tubos de centrífuga
◦ Tubos Eppendorf de 1.5ml
◦ Cap-o-test
◦ Propipetas
◦ Peras para buretas
◦ Bulbos
◦ Gradillas para tubos
◦ Gradillas para puntas de micropipetas
◦ Puntas para micropipetas
◦ Soportes para micropipetas
◦ Tapones de goma
◦ Adaptadores de neopreno para filtración
◦ Bombas para trasegar tambores
◦ Botellas tapa rosca
◦ Conos de sedimentación Imhoff
◦ Cucharas plásticas
◦ Clips para uniones esmeriladas
◦ Envases de 10 y 20 lts con llave de paso
◦ Frascos de dilución
◦ Frascos goteros
◦ Manguera de goma látex
◦ Jarras graduadas
◦ Pinza doble para buretas
◦ Pipetas de transferencia de 3ml desechables

Misceláneos
◦ Densímetros
◦ Termómetros
◦ Termohigrómetros
◦ Aplicadores
◦ Aros con nuez
◦ Barras magnéticas
◦ Cepillos
◦ Cestas de alambre
◦ Cinta testigo de esterilización
◦ Copa Ford de viscosidad
◦ Picnómetros de acero inoxidable
◦ Cronómetros
◦ Timers de 3 tiempos
◦ Papel filtro
◦ Membranas de filtración
◦ Dedales de extracción
◦ Electrodos para phmetros
◦ Escurridores de vidriería
◦ Espátulas mango de madera
◦ Microespátulas
◦ Gradillas para tubos
◦ Gatos elevadores
◦ Mecheros
◦ Pinzas de disección
◦ Pinzas de tres dedos con extensión
◦ Nueces dobles
◦ Soportes universales
◦ Pinzas dobles para buretas
◦ Papel de pH
◦ Papel Parafilm
◦ Papel Kraft
◦ Pinzas para crisoles y muflas
◦ Tinitas de aluminio
◦ Platillos de aluminio para balanzas de humedad
◦ Salinómetros
◦ Soportes para pipetas
◦ Tamices en acero inoxidable
◦ Toma muestras
◦ Trípodes
◦ Rejillas de alambre con centro de cerámica
Novedades
Haga click en cada imagen para acceder al respectivo catálogo del producto.

Misión
Proporcionar respuesta rápida y eficiente, tanto en la oferta como en la entrega de artículos vinculados principalmente con el control de la calidad industrial en el área cosmética, alimentaria y farmacéutica, localizando equipos y materiales para uso de laboratorio en el mercado nacional e internacional, de la mejor calidad y precio justo, manteniendo un inventario variado y racional acorde con la demanda, y capacitando a nuestro equipo humano para ofrecer el mayor apoyo actuando como un aliado comercial.


¿Por qué elegirnos?
Contamos con un amplio inventario de productos de alta calidad siempre listos para satisfacer las necesidades de nuestros clientes con rapidez y eficiencia, ya sea que busque reactivos para análisis, instrumentación o equipos para laboratorio. Nuestra amplia experiencia y compromiso con la calidad garantiza que siempre recibirá el material más conveniente para su tarea.
Trabajamos con marcas reconocidas
Estamos permanentemente seleccionando las mejores alternativas en precio/valor buscando economía sin sacrificar la calidad de los equipos y materiales que comercializamos. Trabajamos con marcas que han demostrado su excelencia en la calidad y precisión de sus productos, lo que nos permite confiar en su capacidad para ayudar a nuestros usuarios a ser efectivos y eficientes en sus labores.
Tenemos un amplio inventario
Entre equipos, reactivos y materiales contamos con más de 2000 ítems disponibles para atenderlos de manera inmediata, Desde espectrofotómetros y balanza analíticas hasta gradillas y tubos de ensayo. No deje de consultarnos, seguro tendremos disponible el material que usted necesita.
Ofrecemos un excelente servicio
Nos dedicamos a atender sus requerimientos de la manera más diligente posible, nuestras líneas de contacto están siempre disponibles a su servicio para cualquier consulta, Por cierto, tenemos la alternativa de importar para ustedes materiales o equipos específicos.
Dedicación y variedad
Años de experiencia, los mejores precios, garantía en los equipos, el stock más amplio del centro del país, un equipo humano que le brindará una atención personalizada son los detalles que nos hacen destacar y ser reconocidos entre los mejores proveedores del sector.
Contacto
Ubicación
Sector Manantial, Calle 191, Centro Empresarial del Norte, Naguanagua Galpón Nro. 40, Valencia 2005, Carabobo
Teléfonos
0414-412.34.78
0241-775.13.59
0412-719.65.92






















